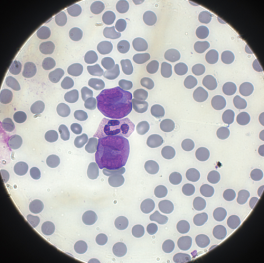

IL CONTENUTO INFORMATIVO DELL’OSSERVAZIONE MORFOLOGICA IN EMATOLOGIA
Tipologia: Convegno ECM, Evento
5 aprile 2025 - ore 9
Sede Confindustria Mantova Sala D - Via Portazzolo 9, Mantova
La proposizione di un corso di base sulla morfologia delle cellule ematiche circolanti rivolto a tutte le categorie di professionisti che possono essere impegnati costantemente od occasionalmente nel settore di Ematologia del Laboratorio Clinico nasce come risposta a varie sollecitazioni
pervenute sul tema dagli operatori stessi.
Come indicato dal titolo, con l’incontro si intende porre l’attenzione, approfondire e verificare l’attuale valore di alcune delle regole di base nell’approccio alla morfologia del sangue periferico.
↬ Leggi il programma completo
ISCRIZIONI
Il numero dei posti è limitato a 100 partecipanti e l'iscrizione è obbligatoria.
Le iscrizioni si effettuano esclusivamente online collegandosi al sito www.intercontact-pesaro.it
SEGRETERIA ORGANIZZATIVA
Provider ECM Accr. Standard Nazionale n. 382
Via Zongo, 45 - 61121 Pesaro, PU
Tel: 072126773 @: l.balducci@intercontact.it
Ultimo aggiornamento: 20/03/2026



